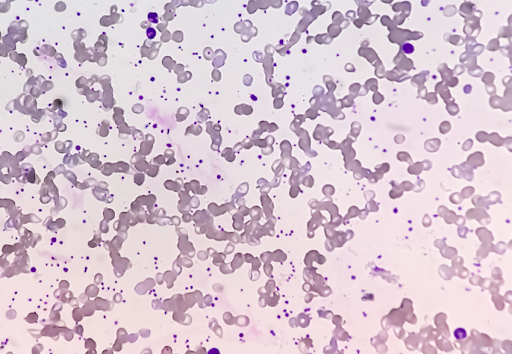
寒冷凝集素症の細胞診検査

寒冷凝集素症という病気を聞いたことがありますか?
犬では
- ミニチュア・ピンシャー
- イタリアン・グレーハウンド
- ミニチュア・ダックスフント
などに多く見られます。
寒冷凝集素症は寒さが関係している病気で、家での予防は一定の効果があると言われています。
今回は予防方法を含め、寒冷凝集素症についてしっかり解説します。
最後まで読んでいただき、早期発見や家での予防をマスターしましょう。
| 📍 目次 ▼ 寒冷凝集素症とは ▼ 寒冷凝集素症に早く気づくためには? ▼ どういう検査が必要? ▼ 寒冷凝集素症の治療 ▼ 家で出来る寒冷凝集素症の予防方法 ▼ まとめ |
寒冷凝集素症とは
寒冷凝集素症は耳の縁や尻尾の先にかさぶたができる病気で、免疫が関わっていると考えられています。
体が寒さに曝されることで体温が下がり、体内の「寒冷凝集素」という抗体が活性化し、赤血球の表面にくっつくことで起こります。
抗体が赤血球の表面にくっつくと赤血球同士が固まったり、体の免疫システムが作動し赤血球を異物と判断して破壊処理します。
赤血球がお互いに固まると血液の流れが悪くなりますし、破壊されれば貧血が起こってしまいます。
寒冷凝集素が活性しやすいかしにくいかは、遺伝的な要因が強いとされています。
しかし、感染症や甲状腺機能低下症などの疾患が寒冷凝集素症を悪化させることもあります。
そのため、これらの病気も併発していないか確認が必要です。
寒冷凝集素症に早く気づくためには?
寒冷凝集素症は赤血球が固まり、血行が悪くなることが原因で起こることで下記の症状がみられます。
- あざ
- かさぶたの形成
- 皮膚の壊死
- 関節の痛み
赤血球が破壊される場合は
- 疲れやすい
- 食欲低下
- 元気の低下
- 尿が赤い
などがみられます。
特にあざや皮膚のかさぶた、壊死は気付きやすい症状で、冷えやすい耳や尾、足の先端で見られます。
そのため、寒い冬の季節に耳の縁や尾の先端が乾燥する場合は注意が必要です。
どういう検査が必要?
寒冷凝集素症の検査は主に皮膚の検査と血液の検査があります。
皮膚の検査では皮膚組織での炎症や赤血球の塊の存在、免疫細胞の出現を確認します。
血液の検査では赤血球がくっついていることや抗体を確認します。
もちろん一般的な身体検査やレントゲン、血液検査、尿検査を同時に行う場合もあります。
どのような検査が必要か、獣医師と相談してくださいね。
寒冷凝集素症の治療
寒冷凝集素症の治療は内科療法とスキンケアに分かれます。
内科療法
内科療法では免疫抑制剤を使用します。
免疫抑制剤は、活性化している抗体に対して過剰に反応している体内の免疫システムを抑えます。
スキンケア
スキンケアは主に血流の改善が目的です。
血流改善にはマッサージやお風呂が効果的で、特にお風呂は炭酸泉などを利用するとその効果をさらに引き上げることが可能です。
ヘパリン類似物質の塗布も効果的です。
ヘパリン類似物質は血行促進作用があり、また抗炎症作用もあります。
家で出来る寒冷凝集素症の予防方法
ペットが苦しむ姿は誰も見たくないですよね。
家でも出来る予防方法をお伝えしますので、ぜひ試してみてください。
適切な食事・運動
適切な食事や運動は体の基礎体力を向上させるだけでなく、血液の流れも良くしてくれます。
そのため、冷えやすい末端にも血が巡りやすくなると言えます。
寒い環境を避ける
寒冷凝集素症は寒い環境で起こる病気です。
冬のお散歩は暖かい日中に行くことや室内ドッグランなどを利用するのもいいかもしれません。
耳を覆える帽子やスヌードの使用
寒冷凝集素症の最も発症しやすい場所である耳を温かくすることは、予防として効果的です。
風が強く耳が冷たくなりやすい日でも帽子やスヌードがあれば安心ですね。

まとめ
いかがでしたでしょうか?
これからの季節は寒くなり、寒冷凝集素症になりやすい季節でもあります。
ぜひ家で出来る予防法を試してみてください。
日頃から動物たちとのコミュニケーションの一環として、体をマッサージしながら耳や尻尾の先端、四肢の先に皮膚の乾燥やあざがないかチェックしましょう。
当院は皮膚科診療に力を入れている病院です。
もし冬に耳の縁や尻尾の先にかさぶたが出来るなど、寒冷凝集素症が疑われる場合はぜひ当院までご相談ください。
よくある質問
Q .犬の寒冷凝集素症はどの犬種に多いのですか?
A .犬の寒冷凝集素症は以下のような小型犬種に多く見られます。
- ミニチュア・ピンシャー
- イタリアン・グレーハウンド
- ミニチュア・ダックスフンド
Q .犬の寒冷凝集素症の症状には何がありますか?
A .犬の寒冷凝集素症は以下のような症状がでます。
- 耳や尻尾の先にあざやかさぶたができる
- 皮膚の壊死
- 関節痛
- 赤血球の破壊による元気消失
- 血尿
Q .犬の寒冷凝集素症はどうやって予防できますか?
A .犬の寒冷凝集素症は以下のような方法で予防します。
- 耳を覆う帽子の使用などの防寒対策
- 血行を良くするための適度な運動
- バランスの取れた食事
寒い日の散歩は暖かい時間帯に行い、スヌードなどで耳を保護してあげましょう。
🎪サーカス動物病院グループの皮膚科の詳細はコチラからご覧いただけます。
📱 WEB予約
💡 予約状況が確認でき、24時間いつでも受付可能なWEB予約がオススメです。


